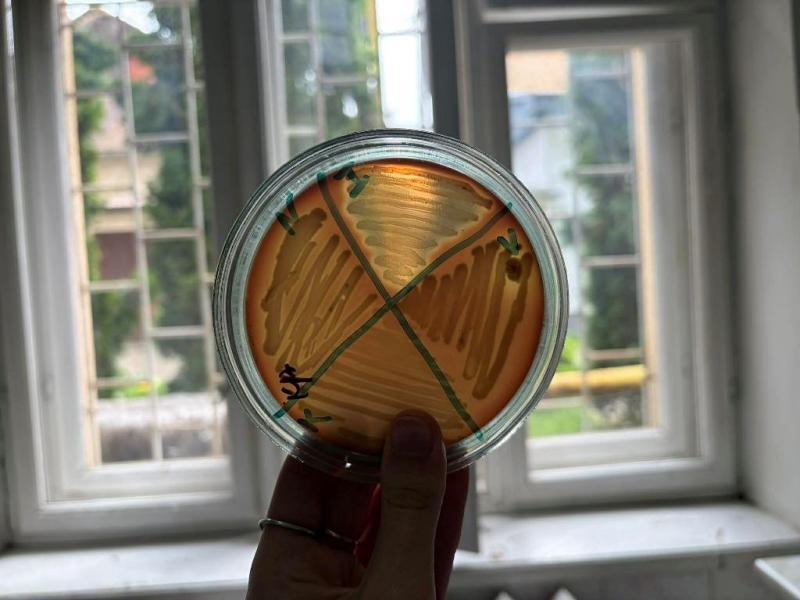

Інвазійні види Закарпаття у фокусі проєкту EFFUSE-win: міждисциплінарний підхід

Упродовж вегетаційного сезону було зібрано значний обсяг польового матеріалу під час маршрутних обстежень, відбору проб та спостережень за розвитком природних угруповань у різних біотопах регіону. Зібрані та ідентифіковані зразки, дані польових спостережень стали основою для подальших лабораторних досліджень, аналітичної обробки та систематизації результатів.
Експерти-зоологи проводять лабораторні дослідження, зосереджуючись на інвазійних хребетних і безхребетних тваринах, зокрема чебачок амурський, ротан головешка, червоновуха черепаха та інші. Результати їхньої роботи дозволять детально проаналізувати поведінкові адаптації та механізми поширення чужорідних видів, які витісняють аборигенні.
Паралельно експерти-ботаніки досліджують інвазійні види вищих судинних рослин, серед яких борщівник Сосновського, амброзія полинолиста, гречка японська, види родів соняшник, золотушник та інші. Вони аналізують їхнє поширення, ступінь впливу на місцеві рослинні угруповання та здатність не тільки трансформовувати, а також формувати нові не типові для регіону рослинні угруповання.
Важливу роль у проєкті відіграють експерти-мікробіологи, які вивчають мікроорганізми, що супроводжують чужорідні види або самі виступають інвазійними агентами. Їхні дослідження спрямовані на виявлення патогенів, аналіз змін мікробіомів екосистем і оцінку потенційних ризиків для здоров’я людей, тварин і рослин.
До спільної роботи також долучені експерти-екологи, які досліджують водні екосистеми, зокрема річку Уж. Вони здійснюють моніторинг якості води, зокрема аналізують її фізико-хімічні показники (рівень кислотності, вміст розчиненого кисню, мінералізацію, температуру, концентрацію біогенних елементів і потенційних забруднювачів), а також оцінюють наслідки антропогенного навантаження. Це дозволяє комплексно оцінити стан річкової екосистеми та визначити ключові загрози для її стабільності.
Об’єднання зусиль зоологів, ботаніків, мікробіологів та екологів забезпечує міждисциплінарний підхід до вивчення біологічних інвазій. Така співпраця дає змогу не лише глибше зрозуміти процеси поширення чужорідних видів на Закарпатті, а й розробити комплексні ефективні стратегії збереження біорізноманіття та підтримання екологічної рівноваги в регіоні.

До теми
- 12 хвилин боротьби за життя: 77-річну ужгородку реанімували після зупинки серця
- Пам’ять дітей, загиблих унаслідок збройної агресії росії проти України, вшанують завтра в обласному центрі
- В Ужгороді вручили свідоцтва випускникам школи мистецтв
- Зібрані поліцією докази забезпечили 11-річний вирок закарпатцю, який налагодив міжрегіональний канал торгівлі амфетаміном
- Фотовиставка «Закарпатська зима» відкрилась в Ужгороді
- На Ужгородщині піротехніки знешкодили мінометну міну часів Другої світової війни
- В Ужгороді поліція затримала чоловіка, який кухонним ножем поранив колишню дружину
- Центр розвитку дитини Пресвятої Богородиці запрацював біля Ужгорода
- Ужгород сьогодні попрощався зі ще одним захисником – 35-річним солдатом Євгенієм Буко
- Завтра в Ужгороді презентуватиме свою книжку відомий військовий репортер зі Словенії
- Укрзалізниця збільшує кількість потягів до Закарпаття цього літа
- За кермом без обмежень: на Закарпатті для людей з інвалідністю представили адаптований транспортний засіб
- В Ужгороді вручили свідоцтва випускникам музичної школи
- В Ужгороді завтра, 1 червня, проведуть в останню земну дорогу захисника Євгенія Буко
- Смертельна ДТП в Ужгороді — поліція відкрила кримінальне провадження
- В Ужгороді внаслідок ДТП травмовано дитину – поліція з’ясовує обставини
- Безпека на воді: рятувальники провели профілактичний рейд на Ужгородському кар’єрі
- 2 роки вважався зниклим безвісти… Ужгород попрощався нині з 32-річним солдатом Мироном Стегурою
- В Ужгороді виявили нетверезу водійку таксі
- Зі ще одним захисником – 46-річним старшим солдатом Олександром Янчієм попрощалися сьогодні в Ужгороді

До цієї новини немає коментарів